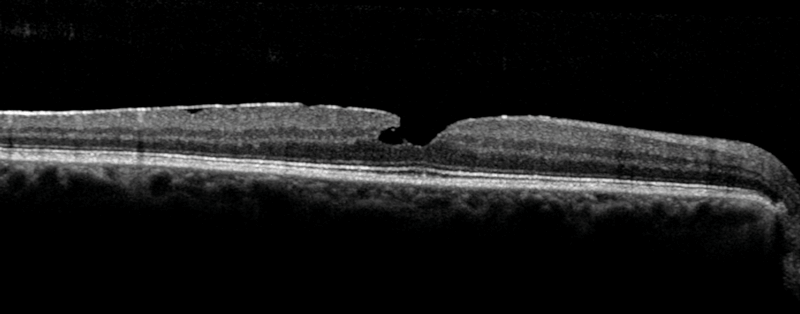

In the next of our articles celebrating 25 years of Eye News, the authors look at how the retina specialty has changed over this time and ask what the future might hold.
Retinal disease management has benefited from great advances in the last 25 years. Globally retinal departments expanded rapidly in response to the changing demographics, advances in therapeutics and the explosion in prevalence of diabetes. Landmark studies have revolutionised the treatment of macular disease. Advances in retinal therapeutics promised much but brought significant challenges in service delivery and a heavy therapeutic burden to our patients.
Retinal imaging illuminated the complex ultrastructure of the retina and delivered advances in phenotyping of macular disease, shaping our understanding of the pathophysiology and progression of the retinal conditions. This in turn has guided treatment and improved prognostication and treatment outcomes for our patients. We have moved from invasive imaging with fluorescein angiography and indocyanine green angiography to the dominance of optical coherence tomography (OCT) and widefield imaging techniques. The most recent addition to the retinal clinic is optical coherence tomography angiography (OCTA), which has brought us full circle. We return to interpreting the intricate neurovascular anatomy of the retina. OCTA provides an impressive display of detailed information on retinal and choroidal vasculature and where blood-flow might be less than optimal, but now we need to meet the challenge of interpreting this information in order to improve patient outcomes further.
The advent of genetic testing helped to characterise retinal diseases with increasing breadth and accuracy, aiding genetic counselling and increasing the accuracy of predicting prognosis of diseases where that was not necessarily possible before. For many decades we have awaited the promise of gene therapy to become a reality. Today we are at the beginning of gene therapy treatments being offered outside the confines of the research clinic. In addition to gene therapy we are at the promising beginning of stem cell treatments. Early phase clinical trials of surgical implantation of stem cells have shown early promise in proof of concept in age-related macular degeneration (AMD).
AMD
Anti-VEGF injections
The landmark ANCHOR and MARINA trials heralded the introduction of anti-VEGF era for AMD. This transformed the outcomes for patients with neovascular macular degeneration and for patients with retinal vascular disorders including retinopathy of prematurity. In AMD, we have moved away from destructive argon laser and photodynamic therapy towards intravitreal anti-VEGF injections. However, the treatment burden in older populations with multiple morbidities and the capacity challenge for the health system should not be underestimated. Delivering monthly intravitreal injections catapulted the already pressured medical retina departments into one of the busiest in any hospital. In response nursing, optometry and orthoptic professionals have been trained by the ophthalmology profession in safe injection technique to improve the chances of delivering an effective service. Infrastructure projects are urgently needed to address the increasing demands on this service and for the projected demands in the next 25 years. The profession eagerly awaits new molecules or new depot delivery methods to reduce the injection burden to our patients and reduce the capacity pressures to our departments. The pharmaceutical industry has already started with early phase trial on a topical anti-VEGF eye drop. We look forward to the results.
Genetics
Currently half of AMD cases have identifiable genetic variants contributing to this complex multifactorial disease. The promise of identifying and targeting these variants may help deliver personalised therapeutics in the future with the hope of improving outcomes and reducing the therapeutic burden.

Figure 1: Image grading for age-related macular degeneration: colour and OCT images.
Intraocular telescopes
Intraocular telescopes are surgically implantable low vision aids for selected patients. These hold promise for highly motivated patients with a dense central scotoma. In conjunction with intensive low vision support these devices can support suitable patients to regain some visual function.
Stem cells
Stem cell therapy has been awaited with great anticipation as a solution to degenerative disease. Surgical implantation of stem cells has recently been demonstrated as a potential hope for patients in early phase clinical trials. This surgical trial demonstrated the proof of concept with the survival of retinal pigment epithelium (RPE) cells 12 months post implantation.
Retinal vascular disease
Diabetic retinopathy is the leading cause of vision loss in adults of working age. Over the last 25 years the World Health Organization (WHO) has reported the prevalence of diabetes to be rising rapidly. One in three patients with diabetes have detectable diabetic retinopathy. Unfortunately, 10% of patients with diabetes will develop a sight-threatening complication. The ophthalmic profession, in the UK especially, responded by developing one of the most successful screening programmes in the sphere of public health.
Diabetic retinopathy screening successfully delivered a cost-effective reduction in blindness. In 1999 the Department of Health and the Royal College of Ophthalmologists discussed the introduction of national diabetic retinopathy screening. This was the basis for modern day dilated fundal retinal photography and training and accreditation of specialist teams of retinal photographers and graders.
Anti-VEGF injections revolutionised visual outcomes for retinal vein occlusion and diabetic retinopathy. The evidence supports treatment in diabetic macular oedema and in some cases proliferative diabetic retinopathy. However, the cost-effectiveness of anti-VEGF treatment and the repeated nature of the injection therapies meant that injection therapy has not overtaken laser photocoagulation for proliferative diabetic retinopathy at this point.
Developments in laser platforms have been dominated by the arrival of pattern laser machines and micropulse laser systems. These have been designed to provide more burns more speedily for the operator and with less pain for the patients. We eagerly look forward to developments in laser technology which provide increased patient comfort with better patient outcomes and uses more pre-planning and automation to develop the correct amount of burns safely.
Steroid implants for intravitreal injections have a place in retinal vascular disorders. They have not been as widely used as the anti-VEGF injections, however, they do have the advantage of a longer therapeutic window and less frequent injection schedule. However, the side-effects of cataract and glaucoma is limiting the use of these agents at present. We are increasingly seeing the use of long-acting steroid implants in non infectious uveitis and we look forward to these developments with interest.
Retinal dystrophy
Genetic characterisation of retinal disease delivered diagnosis, prognosis and, in selected cases, treatment. One of the most dramatic examples is the RPE65 gene trial. This research developed a gene therapy for patients with RPE65 mutations causing Leber congenital amaurosis and retinitis pigmentosa. The video presentation of the improvement in maze navigation in the RPE65 patient demonstrates the functional improvement in dramatic fashion. There is increasing interest in the subretinal delivery of genetic therapy with viral vectors delivered with vitreoretinal surgical techniques.
Argus subretinal implant is an electronic subretinal implant for selected patients with severe cases of retinitis pigmentosa. It has also been referred to as the bionic eye. It has been shown to provide some increase in vision after surgical implantation.
“The diabetes crisis requires both a public health and a technology revolution.”
Uveitis
Over the last 25 years the grim natural history of chronic uveitis presented ophthalmology with significant challenges both medically and surgically. The advent of biologics dramatically changed the outcomes for noninfectious uveitis. In addition, the long-acting steroid delivery platforms have evolved from invasive surgical implant to repeatable injectables.
Figure 2: OCT image of a macular hole.
Retinal imaging
Optical coherence tomography
OCT moved rapidly from the research lab to being an essential part of the medical retina clinic. In most cases it replaced the time- consuming and invasive retinal angiography techniques to noninvasive in vivo imaging completed in a matter of seconds. OCT increased capacity, sped up treatment pathways and avoided the side-effects from intravenous injection for our patients, and while angiography is still necessary in some cases, many patients benefit from OCT based diagnostics. Over the last 25 years the technology has dramatically improved the resolution of the retinal images. The images OCT provides can be viewed in two or three dimensions. In response, ophthalmologists had to develop their understanding and interpretation of these images in the context of a rapidly developing area of retinal therapeutics. The availability of OCT expanded the capabilities of our retinal imaging departments and provided a cadre of healthcare professionals with training, accreditation and career pathway. Having OCT and the trained workforce allowed us to set up virtual clinics and explore the benefits of telemedicine.
OCT angiography
OCTA has been discussed more recently as a new tool to image the retinal vascular ultrastructure by visualising bloodflow in multiple layers of the retina, which can then be examined individually. OCTA detects choroidal neovascular membranes, especially if they are positioned in front of the RPE. This technique, as with normal SD-OCT, cannot detect leak. Clinically, it is inferred from the changes in structure. So OCT has not completely replaced retinal angiography when leakage is deemed to be important and needs to be examined.
Widefield imaging
There are multiple retinal imaging platforms, which now provide widefield retinal imaging. These provided improved visualisation of the peripheral retinal and increased our knowledge of the importance of the peripheral retinal pathophysiology especially in retinal vascular disease. It is important to note that the widefield imaging has not yet been able to visualise the ora serrata 360 degrees with a single image. It cannot replace the clinical skill of indirect ophthalmoscopy to visualise the entire retina, but it provides close enough approximation so its use in telemedicine is improving.
The future
The changing patient demographics are bringing major demands, which we hope are rapidly met with advances in biotechnology. We need a solution to the treatment burden of the anti-VEGF era. The anti-VEGF success of this past decade will hopefully drive rapid advances. The diabetes crisis requires both a public health and a technology revolution in the treatment of obesity and diabetic complications. The beginnings of genetic and uveitis therapies are much needed and very exciting. Historically, these patients have had a high risk of sight-threatening complications. We are continually learning about the retinal microenvironment and delivery of retinal therapies.
In conclusion, the future of medical retina looks bright but busy. The patient numbers will increase inexorably in the coming decades. Increasing complexity and new technology will likely create the demand for further subspecialisation within medical retina training. Increasing advanced practitioner roles with our multidisciplinary colleagues and virtual medicine may help tackle the capacity issues, however, our patients need the health system to recognise and action resource allocation urgently. The success, clinical and financial, of the anti-VEGF therapies has created an expectation within the ophthalmology community of the next big paradigm change. However, it is currently unclear when this will appear and what it will be. We look forward to the next 25 years in medical retina with great interest and anticipation.
Declaration of competing interests: None declared.
COMMENTS ARE WELCOME